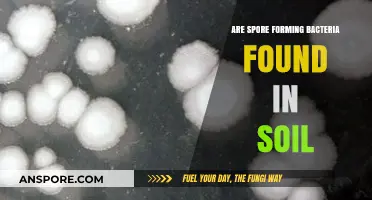
Exploring Soil: Are Spore-Forming Bacteria Common in Earth's Layers?

Spore-based probiotics have gained attention in recent years as a potentially superior alternative to traditional probiotics, primarily due to their unique ability to survive the harsh conditions of the gastrointestinal tract, including stomach acid and bile. Unlike conventional probiotics, which often contain live bacteria that may not fully reach the intestines, spore-based probiotics consist of dormant bacterial spores that activate once they reach the gut, ensuring higher viability and efficacy. Additionally, these spores are believed to support gut health by promoting a balanced microbiome, enhancing immune function, and reducing inflammation. However, while research suggests promising benefits, the question remains whether spore-based probiotics truly outperform traditional strains, warranting further investigation into their long-term effects and optimal applications.
| Characteristics | Values |
|---|---|
| Stability | Highly stable; resistant to heat, light, and stomach acid degradation. |
| Shelf Life | Longer shelf life compared to non-spore probiotics; no refrigeration needed. |
| Survival in Gut | Better survival through the gastrointestinal tract due to spore form. |
| Immune System Support | Enhances immune function by modulating gut microbiota and reducing inflammation. |
| Antibiotic Resistance | Less affected by antibiotics; can coexist with antibiotic treatment. |
| Gut Barrier Integrity | Supports and strengthens the intestinal barrier. |
| Effectiveness in Dysbiosis | Effective in restoring gut balance in cases of dysbiosis. |
| Allergen-Free | Generally hypoallergenic and suitable for sensitive individuals. |
| Colony Formation | Spores germinate and colonize the gut temporarily, producing beneficial bacteria. |
| Cost | Often more expensive than traditional probiotics. |
| Research Support | Growing evidence supports efficacy, but more research is needed for long-term benefits. |
| Strains Commonly Used | Bacillus subtilis, Bacillus coagulans, Bacillus clausii. |
| Side Effects | Minimal side effects; rare cases of bloating or gas in sensitive individuals. |
| Targeted Benefits | Focused on gut health, digestion, and immune support. |
| Compatibility with Diet | Suitable for vegan, keto, and other dietary restrictions. |
| Environmental Impact | Lower environmental footprint due to longer shelf life and reduced waste. |
Explore related products
What You'll Learn

Spore vs. Traditional Probiotics: Key Differences
Spore-based probiotics and traditional probiotics differ fundamentally in their structure and survival mechanisms. Unlike traditional probiotics, which consist of live, active bacteria like Lactobacillus and Bifidobacterium, spore-based probiotics contain bacterial spores—dormant, protective forms of Bacillus species. These spores are encased in a tough outer shell, allowing them to withstand harsh environments, including stomach acid and high temperatures. Traditional probiotics, however, are more fragile and often require enteric coatings or refrigeration to remain viable. This inherent resilience makes spore-based probiotics more likely to reach the intestines intact, where they can colonize and exert their effects.
Consider the practical implications of this difference. Traditional probiotics typically require a daily dose of 10–50 billion CFUs (colony-forming units) to ensure enough bacteria survive the digestive process. Spore-based probiotics, on the other hand, are effective at much lower doses, often ranging from 1–5 billion CFUs. For example, a common spore-based supplement might recommend just one capsule daily, while a traditional probiotic may require two or more. This makes spore-based options more convenient for those who struggle with adherence or prefer a simpler regimen.
Another key distinction lies in their mechanisms of action. Traditional probiotics work primarily by colonizing the gut and competing with harmful bacteria for resources. Spore-based probiotics, however, operate differently—they remain in spore form until they reach the intestines, where they germinate and produce beneficial byproducts like enzymes and short-chain fatty acids. These byproducts support gut health by reducing inflammation and improving nutrient absorption. For instance, Bacillus coagulans, a common spore-based strain, has been shown to alleviate symptoms of irritable bowel syndrome (IBS) and enhance immune function in clinical studies.
Age and health status also play a role in choosing between the two. Traditional probiotics are often recommended for general gut maintenance in healthy adults and children over 12, but their efficacy can vary depending on individual gut microbiomes. Spore-based probiotics, with their targeted action and durability, are particularly beneficial for individuals with compromised gut barriers, such as those recovering from antibiotic use or suffering from chronic digestive disorders. For children under 12 or those with specific health conditions, consulting a healthcare provider is essential to determine the appropriate type and dosage.
In conclusion, the choice between spore-based and traditional probiotics hinges on specific needs and circumstances. If convenience, shelf stability, and targeted gut support are priorities, spore-based probiotics offer a compelling advantage. However, for those seeking broad-spectrum bacterial diversity and willing to manage storage and dosage carefully, traditional probiotics remain a viable option. Understanding these key differences empowers individuals to make informed decisions tailored to their health goals.
Are Mold Spores Carcinogens? Uncovering the Health Risks and Facts
You may want to see also

Survival Rates in Gut Environment
Spore-based probiotics have gained attention for their resilience in harsh environments, a critical factor when navigating the complex terrain of the human gut. Unlike traditional probiotics, which often struggle to survive stomach acid and bile salts, spore-based strains, such as *Bacillus subtilis* and *Bacillus coagulans*, enter a protective dormant state, enhancing their survival rates. This natural armor allows them to reach the intestines intact, where they can germinate and exert their beneficial effects. Studies show that up to 90% of spore-based probiotics survive the gastrointestinal journey, compared to 5-20% of non-spore strains, making them a more reliable option for gut colonization.
To maximize the survival and efficacy of spore-based probiotics, timing and dosage play pivotal roles. Taking these supplements with a meal, particularly one containing fats, can buffer stomach acid and further protect the spores. A typical dosage ranges from 1 to 5 billion CFUs (colony-forming units) daily, depending on the specific strain and individual health goals. For instance, *Bacillus coagulans* at 2 billion CFUs has been shown to improve gut health in adults, while *Bacillus clausii* is often prescribed in higher doses for children to combat diarrhea. Always consult a healthcare provider to tailor the dosage to your needs, especially for vulnerable populations like the elderly or immunocompromised individuals.
A comparative analysis reveals that spore-based probiotics not only survive better but also thrive in the gut environment, offering sustained benefits. Traditional probiotics, such as *Lactobacillus* and *Bifidobacterium*, often require refrigeration and have a shorter shelf life due to their fragility. In contrast, spore-based probiotics are shelf-stable and can withstand extreme temperatures, making them more convenient for daily use. Their ability to remain dormant until reaching the intestines ensures consistent delivery of live bacteria, which is essential for rebalancing gut microbiota and supporting immune function.
Practical tips for optimizing spore-based probiotic survival include avoiding consumption with hot beverages or alcohol, which can activate spores prematurely. Pairing them with prebiotic fibers, such as inulin or chicory root, can enhance their germination and activity in the gut. For those with sensitive stomachs, starting with a lower dose and gradually increasing it can minimize potential side effects like bloating. Monitoring your body’s response over 2-4 weeks will help determine the effectiveness of the supplement, as improvements in digestion, immunity, and overall well-being are common indicators of successful gut colonization.
In conclusion, the superior survival rates of spore-based probiotics in the gut environment make them a compelling choice for those seeking reliable and effective microbial support. Their resilience to stomach acid, bile salts, and environmental stressors ensures that a higher percentage of spores reach their target site, where they can exert their health-promoting effects. By understanding dosage, timing, and complementary strategies, individuals can maximize the benefits of these robust strains, paving the way for a healthier gut and improved overall wellness.
C. Diff Spores Survival: How Long Do They Live on Surfaces?
You may want to see also

Immune System Impact Comparison
Spore-based probiotics, unlike their traditional counterparts, contain bacteria in a dormant, spore form, allowing them to survive the harsh stomach acid environment and reach the intestines intact. This unique characteristic raises questions about their impact on the immune system compared to conventional probiotics.
Mechanisms of Action:
Traditional probiotics, often containing strains like Lactobacillus and Bifidobacterium, primarily work by colonizing the gut and competing with harmful bacteria for resources. They produce beneficial metabolites like short-chain fatty acids, which can modulate immune responses. Spore-based probiotics, on the other hand, act more as "messengers," stimulating the gut's own immune cells and promoting a balanced immune response. They achieve this through their ability to interact with toll-like receptors on immune cells, triggering a cascade of signaling events.
Clinical Evidence:
While research is ongoing, studies suggest both types of probiotics can positively influence immune function. Traditional probiotics have shown promise in reducing the incidence and severity of respiratory infections, particularly in children and the elderly. A 2015 meta-analysis found that certain strains reduced the duration of common cold symptoms by 1.5 days. Spore-based probiotics, though with less extensive research, have demonstrated potential in modulating inflammatory responses and enhancing immune cell activity. A 2018 study showed that a specific spore-based probiotic strain increased the production of anti-inflammatory cytokines in healthy adults.
Dosage and Considerations:
Dosage recommendations vary depending on the specific strain and product. Generally, traditional probiotics range from 1-10 billion CFUs (colony forming units) per day, while spore-based probiotics typically require lower doses, often in the range of 1-5 billion CFUs. It's crucial to follow the manufacturer's instructions and consult a healthcare professional, especially if you have underlying health conditions or are taking medications.
Practical Tips:
- Consistency is Key: For both types, consistent daily intake is essential for optimal results.
- Timing Matters: Take probiotics with or after meals to enhance survival through the stomach.
- Storage: Follow storage instructions carefully, as some probiotics require refrigeration.
- Individual Variability: Responses to probiotics can vary. Monitor your own experience and adjust dosage or strain if necessary.
Ultimately, the choice between spore-based and traditional probiotics depends on individual needs and preferences. While both offer potential immune benefits, spore-based probiotics' unique mechanism of action and survival advantages make them a compelling option for those seeking targeted immune support. Further research is needed to fully understand their long-term effects and optimal applications.
Do Ferns Produce Spores? Unveiling the Reproduction Secrets of Ferns
You may want to see also
Explore related products

Shelf Stability and Longevity
Spore-based probiotics stand out in the realm of gut health supplements due to their exceptional shelf stability and longevity. Unlike traditional probiotics, which often require refrigeration to maintain viability, spore-based strains can survive harsh conditions, including extreme temperatures, pH levels, and even the rigors of manufacturing processes. This resilience translates to a longer shelf life, often measured in years rather than months, making them a reliable choice for consumers and manufacturers alike.
Consider the practical implications: a spore-based probiotic supplement can sit on a store shelf or in your pantry without losing potency, eliminating the need for constant refrigeration. This is particularly advantageous for travelers or those with limited access to cold storage. For instance, a study published in the *Journal of Probiotics & Health* highlighted that Bacillus coagulans, a common spore-based strain, retained 95% of its viability after two years at room temperature. Compare this to non-spore probiotics, which may lose up to 50% of their potency within six months under similar conditions.
However, shelf stability isn’t just about convenience—it’s also about efficacy. When probiotics degrade, their colony-forming units (CFUs) decrease, potentially rendering them ineffective. Spore-based probiotics, with their protective endospore coating, ensure that the CFU count remains consistent over time. For optimal results, look for products with a guaranteed potency of at least 1 billion CFUs per serving, even after the expiration date. This is especially critical for individuals addressing specific health concerns, such as digestive disorders or immune support, where precise dosing matters.
A cautionary note: while spore-based probiotics are robust, they are not invincible. Exposure to moisture or extreme environmental conditions can still compromise their integrity. Always store them in a cool, dry place, and avoid transferring them to unsealed containers. Additionally, check the manufacturing date and choose products with a clear expiration date to ensure maximum potency. For those over 50 or with compromised immune systems, consulting a healthcare provider before starting any probiotic regimen is advisable.
In conclusion, the shelf stability and longevity of spore-based probiotics make them a superior choice for those seeking a reliable, long-lasting supplement. Their ability to withstand time and environmental challenges ensures consistent efficacy, providing peace of mind and practical benefits for users. Whether you’re a frequent traveler, a busy professional, or simply someone who values convenience, spore-based probiotics offer a durable solution for maintaining gut health without the hassle of refrigeration or frequent repurchasing.
Exploring the Surprising Diversity Among Commonly Assumed Similar Spores
You may want to see also

Clinical Efficacy Studies Overview
Spore-based probiotics have gained attention for their potential to survive the harsh conditions of the gastrointestinal tract, but their clinical efficacy remains a critical area of investigation. Studies have explored their impact on gut health, immune function, and specific conditions like irritable bowel syndrome (IBS) and antibiotic-associated diarrhea. For instance, a randomized controlled trial published in the *Journal of Clinical Gastroenterology* found that a daily dose of 2 billion CFU of *Bacillus coagulans* MTCC 5856 significantly reduced bloating and abdominal pain in IBS patients over 8 weeks. This highlights the importance of strain-specific research, as not all spore-based probiotics yield consistent results.
Analyzing the methodology of these studies reveals common challenges. Many trials lack long-term follow-up, making it difficult to assess sustained benefits. Dosage variability is another issue; some studies use 1 billion CFU daily, while others administer up to 5 billion CFU, complicating comparisons. Age-specific efficacy is also underexplored, with most trials focusing on adults aged 18–65. Pediatric and elderly populations, who may have distinct gut microbiomes, are often underrepresented. Researchers must standardize protocols to ensure reliable conclusions about spore-based probiotics’ effectiveness.
Persuasive arguments for spore-based probiotics often emphasize their resilience, but clinical data must support these claims. A meta-analysis in *Frontiers in Microbiology* concluded that spore-forming strains like *Bacillus subtilis* and *Bacillus clausii* show promise in reducing diarrhea duration by 1–2 days in antibiotic-associated cases. However, these findings are not universal; some studies report no significant difference compared to placebo. Practical tips for consumers include verifying the strain’s clinical backing and ensuring products are stored correctly, as exposure to moisture or heat can compromise spore viability.
Comparatively, spore-based probiotics differ from non-spore strains in their ability to remain dormant until reaching the intestines, theoretically enhancing efficacy. Yet, this advantage is not always reflected in outcomes. For example, a study in *Gut Microbes* found that *Lactobacillus rhamnosus* GG, a non-spore probiotic, outperformed *Bacillus subtilis* in alleviating constipation in children. This underscores the need to evaluate spore-based probiotics within the context of specific health goals rather than assuming superiority based on mechanism alone.
Descriptive insights from recent trials offer a nuanced view. A 12-week study involving 100 participants with mild to moderate constipation demonstrated that a combination of *Bacillus subtilis* and *Bacillus coagulans* at 3 billion CFU daily improved bowel movement frequency by 30%. However, adherence was a challenge, with 15% of participants reporting difficulty incorporating the supplement into their routine. Such findings emphasize the interplay between clinical efficacy and real-world usability, suggesting that even effective strains may require lifestyle adjustments for optimal results.
Are All Psilocybe Spore Prints Purple? Unveiling the Truth
You may want to see also
Frequently asked questions
Spore-based probiotics are not inherently "better," but they offer unique advantages. They are more resistant to stomach acid, ensuring better survival to the intestines, and do not require refrigeration. However, the best choice depends on individual health needs and goals.
Spore-based probiotics can support gut health by promoting a balanced microbiome and enhancing gut barrier function. Their durability makes them effective for some individuals, but results vary, and traditional probiotics may be more suitable for others.
Spore-based probiotics are generally safe for most people, but individuals with compromised immune systems or specific health conditions should consult a healthcare provider before use.
Spore-based probiotics offer benefits like improved shelf stability and survival in the gut, but traditional probiotics may provide a broader range of strains. The choice depends on personal health objectives and preferences.